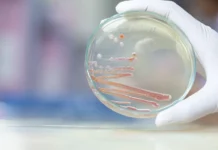
Новокузнецк борется с Serratia marcescens: защита новорожденных novokuzneczk boretsya s zashhita novorozhdennyh-todey-ru-0

В последние годы родильный дом города Новокузнецк, расположенного на юге Кемеровской области, оказался в центре внимания из-за необычайно высокого числа пациенток, поступающих со всего региона. Жительница Кузбасса Анастасия Бабушкина, которая стала мамой двоих детей в стенах этого медицинского учреждения, поделилась своим личным опытом и размышлениями о ситуации, сложившейся в роддоме. Несмотря на сложности, она отмечает по-настоящему профессиональный и человечный подход со стороны медицинского персонала.
Причины высокого потока рожениц в роддоме Новокузнецка
По словам Анастасии Бабушкиной, особенность Новокузнецкого роддома в том, что он принимает пациенток не только из самого города, но и из небольших населённых пунктов по всему югу области. В последние годы многие роддома в малых городах, таких как Осинники и Мыски, были закрыты, а в Калтане и вовсе перестали функционировать профильные отделения. В Белово даже не было своего родильного дома, из-за чего всех женщин с беременностью и необходимостью наблюдения или родов отправляют именно в Новокузнецк.
Бабушкина отмечает, что сложные и экстренные случаи, связанные с патологиями или рисками для будущей мамы и новорождённого, часто требуют немедленной госпитализации. Однако малые города не имеют достаточного количества специалистов, оборудования и соответствующих условий. Это приводит к тому, что медицинские работники предпочитают не рисковать — пациенток оперативно направляют в крупный родильный центр, обладающий всеми необходимыми ресурсами для оказания квалифицированной медицинской помощи.
Повышенный поток рожениц усугубляет ситуацию, создавая определённые трудности и для персонала, и для пациенток. Тем не менее, Анастасия уверяет: «Медицинский коллектив всегда находил возможность уделить внимание каждой женщине — и профессионально, и по-человечески. Мне помогали, поддерживали, давали советы. Я не сталкивалась там ни с грубостью, ни с равнодушием».
Проблемы бытового характера и отношение персонала
Анастасия рожала своих детей в 2015 и 2017 годах. Она делится, что в случае с большим числом поступивших женщин стало сложнее поддерживать безупречную чистоту в помещениях. По её воспоминаниям, коридоры и палаты иногда были не столь ухожены, как хотелось бы. Её удивило даже появление тараканов — очевидно, нагрузка на учреждение вызывала перебои в работе служб, отвечающих за санитарное состояние.
Однако женщина подчёркивает, что на фоне санитарных трудностей главное — профессионализм и доброжелательность персонала. «Конечно, хотелось бы лучших бытовых условий, но я не могу сказать ни одного плохого слова о врачах и акушерках. Они делали всё возможное для здоровья детей и комфорта молодых мам», — рассказывает Анастасия.
Она отмечает, что поток женщин иногда приводил к тому, что не хватало свободных коек, приходилось дожидаться санитарной обработки палат, но ни одна женщина не оставалась без медицинского внимания. Команда врачей, несмотря на усталость и многозадачность, находила время и силы поддерживать каждую пациентку словом и делом.
Надежда на дальнейшие улучшения в родовспоможении Кузбасса
В январе внимание общественности вновь привлекли трагические события — стало известно о тяжелых случаях среди новорождённых. По словам Бабушкиной, такие ситуации требуют комплексных решений — не только поддержки персонала, но и государственного внимания к состоянию учреждений, техническому оснащению и кадровому наполнению.
Однако её рассказы наполнены оптимизмом и верой в позитивные перемены: «Уверена, что благодаря усилиям местных властей и заботе врачей роддом станет только лучше. Мамы из всей области будут получать всё необходимое для комфортных и безопасных родов. Главное — не оставаться равнодушными и продолжать совершенствовать систему родовспоможения».
Анастасия подчеркнула, что опыт родов в Новокузнецке, несмотря на некоторые бытовые недочёты и сложности, дал ей главное — здоровых детей и веру в профессионализм местных специалистов. Она рекомендует другим женщинам не бояться обращаться именно в этот роддом, если потребуется квалифицированная медицинская помощь.
Рассуждая о будущем, Бабушкина выразила надежду, что постепенно каждый город региона сможет вновь открыть свои отделения родовспоможения, а для действующего роддома появятся расширение штатного расписания, обновление оборудования и привлечение молодых талантливых врачей. В своих отзывах она делает акцент именно на заслугах коллектива, который продолжает самоотверженно помогать роженицам и их детям, несмотря ни на какие трудности.
Источник: lenta.ru